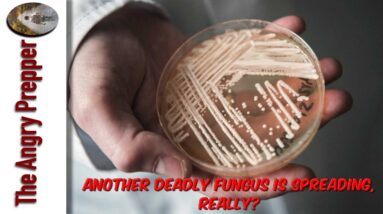
Another Deadly Fungus Is Spreading? Really!

Exploring the Tranquil Wilderness: A Solo June Garden Tour and Off-Grid Adventure
$rfsn_creative.generate(‘refersion_client/25365/creatives/dynamic/59043-d74ed1fe88707819ef57b8a8a914823f.json’, { aid: ‘5660739.366b98′ }); Title: Exploring the Tranquil Wilderness: A Solo June Garden Tour and Off-Grid Adventure | Off Grid w/ Jake & Nicolle’s Vlog 171 Watch This Video How To Have Power When No One Else Does or…

Discover the Efficient Vesta Heater and Stove by InstaFire: My Patriot Supply
$rfsn_creative.generate(‘refersion_client/25365/creatives/dynamic/59043-d74ed1fe88707819ef57b8a8a914823f.json’, { aid: ‘5660739.366b98’ }); Introduction Watch This Video How To Have Power When No One Else Does or Can Find Out Why You Need This Holster Try Our Exclusive Preparedness Survival Shake Mix For FREE Unlock & Maximze Your…

Stay Alert: The Biggest Attack is on the Horizon.
Stay Alert: The Biggest Attack is on the Horizon Introduction $rfsn_creative.generate(‘refersion_client/25365/creatives/dynamic/59043-d74ed1fe88707819ef57b8a8a914823f.json’, { aid: ‘5660739.366b98’ }); As we approach the year 2023, we cannot overlook the growing economic and political challenges facing individuals and businesses worldwide. The news update for May…

Survival in forest: Found many crabs and egg for food in forest – Crab and egg cooking for lunch
$rfsn_creative.generate(‘refersion_client/25365/creatives/dynamic/59043-d74ed1fe88707819ef57b8a8a914823f.json’, { aid: ‘5660739.366b98’ }); Surviving in the forest can be a challenge, but it can also be an opportunity to find unique sources of food. During my recent expedition, I stumbled upon a bounty of crabs and eggs, which…

COVERED in SNOW – EXPENSIVE SEA SALT, HOW I MAKE IT for FREE | DIVING for HUGE SCALLOPS – Ep. 168
Foreign [Music] [Music] Thank you [Music] Foreign Foreign I get a break Are we getting ready to go on an Adventure But Tons and steering wheels yeah [Music] We’re gonna go foraging we’re gonna go Forge for some stuff [Music]…

Storing and Organizing Seeds #preparedness #prepper # Gardening
So you're probably a lot better at Organizing seeds than I am but every Year when it comes to springtime I'm Always searching around sorry if the Chickens are being loud right now but They're joining in but I found…